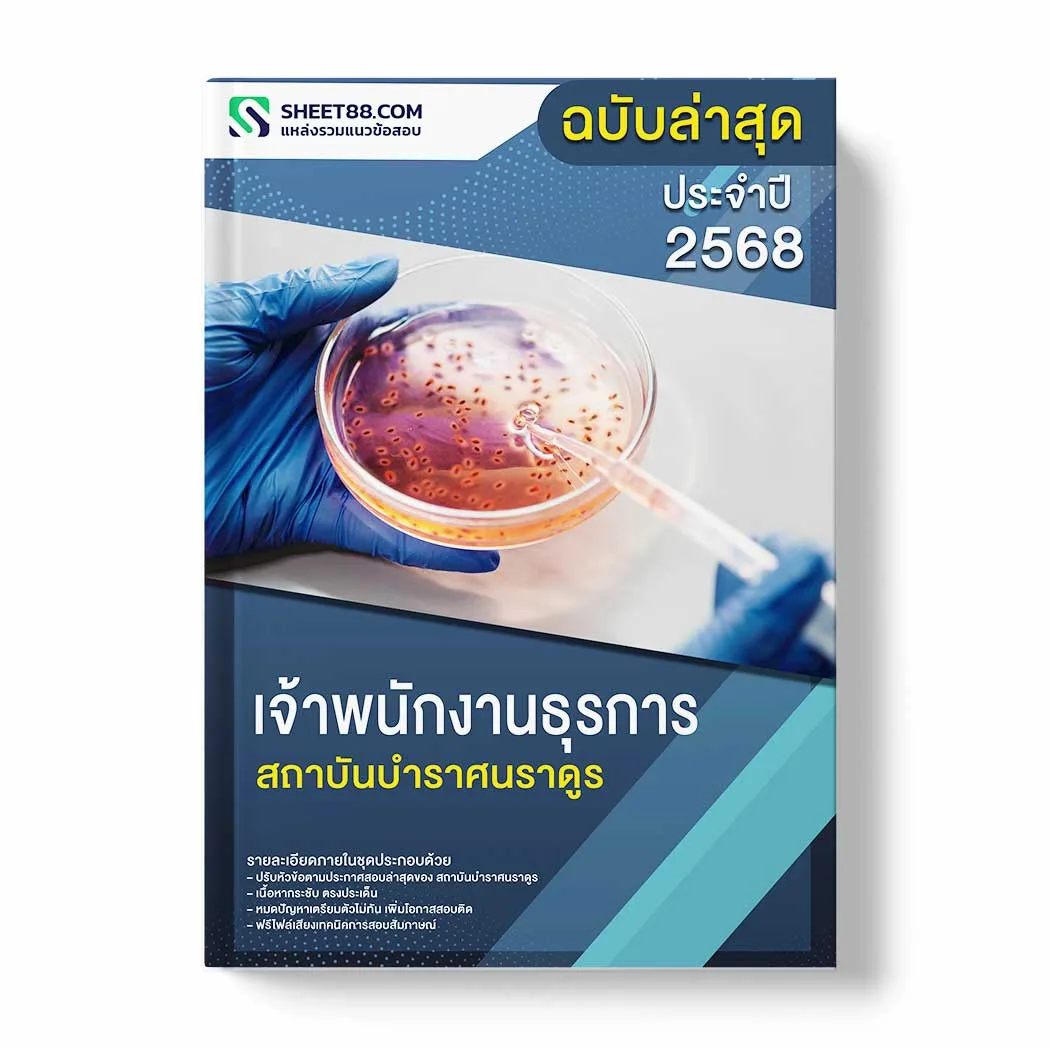

แนวข้อสอบ เจ้าพนักงานธุรการ สถาบันบําราศนราดูร
฿380
รายละเอียดภายในชุด แนวข้อสอบ เจ้าพนักงานธุรการ สถาบันบําราศนราดูร PDFและหนังสือ ประกอบด้วย
– ปรับหัวข้อตามประกาศสอบล่าสุดของ สถาบันบําราศนราดูร
– เนื้อหากระชับ ตรงประเด็น
– หมดปัญหาเตรียมตัวไม่ทัน เพิ่มโอกาสสอบติด
– ฟรีไฟล์เสียงเทคนิคการสอบสัมภาษณ์
รายละเอียดสินค้า
แนวข้อสอบ เจ้าพนักงานธุรการ สถาบันบําราศนราดูร พร้อมเฉลยข้อสอบ 2568
– ความรู้เกี่ยวกับสถาบันบําราศนราดูร
– แนวข้อสอบความรู้ความสามารถทั่วไป
– แนวข้อสอบเจ้าพนักงานธุรการ
– ความรู้เกี่ยวกับระเบียบสำนักนายกรัฐมนตรีว่าด้วยงานสารบรรณ พ.ศ.2526 และที่แก้ไขเพิ่มเติม
– ความรู้เกี่ยวกับพระราชบัญญัติข้อมูลข่าวสารของราชการ พ.ศ.2540
– ความรู้เกี่ยวกับสถาบันบำราศนราดูร
– ความรู้เกี่ยวกับทักษะการเขียนหนังสือราชการ โดยใช้โปรแกรม Microsoft Word
– ความรู้เกี่ยวกับทักษะการจัดการข้อมูล โดยใช้โปรแกรม Microsoft Excel
– ความรู้ความสามารถด้านคอมพิวเตอร์ Microsoft Office : word, Excel, Internet
– ความรู้เกี่ยวกับการใช้คอมพิวเตอร์เบื้องต้นในการปฏิบัติงาน
– แนวข้อสอบ สังคม เศรษฐกิจ การเมืองปัจจุบัน
– เทคนิคการสอบสัมภาษณ์
รายละเอียดภายในชุดสำหรับ เจ้าพนักงานธุรการ สถาบันบําราศนราดูร
– ปรับหัวข้อตามประกาศสอบล่าสุดของ สถาบันบําราศนราดูร
– เนื้อหากระชับ ตรงประเด็น
– หมดปัญหาเตรียมตัวไม่ทัน เพิ่มโอกาสสอบติด
– ฟรีไฟล์เสียงเทคนิคการสอบสัมภาษณ์
รูปแบบการสั่งชื้อสินค้า สรุปข้อสอบ เจ้าพนักงานธุรการ สถาบันบําราศนราดูร
(1). แบบ e-book ราคา 380 บาท ได้รับภายใน 5-20 นาที
(2). แบบหนังสือ ราคา 680 บาท ส่งฟรีด่วนพิเศษ 2-3 วัน
!!!! แถมฟรีไฟล์เสียงเทคนิคการสอบสัมภาษณ์ !!!
แนวข้อสอบ สถาบันบําราศนราดูร พร้อมเฉลย
สนใจสั่งซื้อ แนวข้อสอบ เจ้าพนักงานธุรการ สถาบันบําราศนราดูร ติดต่อที่
โทร: 091-8641493
Line id: @sheet888 มี@ด้วยนะคะ
*** เอกสารชุดนี้จัดทำขึ้นเพื่อการศึกษาและการเตรียมสอบเท่านั้น เนื้อหาเป็นการวิเคราะห์และเก็งแนวข้อสอบโดยผู้เรียบเรียง มิใช่ข้อสอบจริงจากหน่วยงาน ***